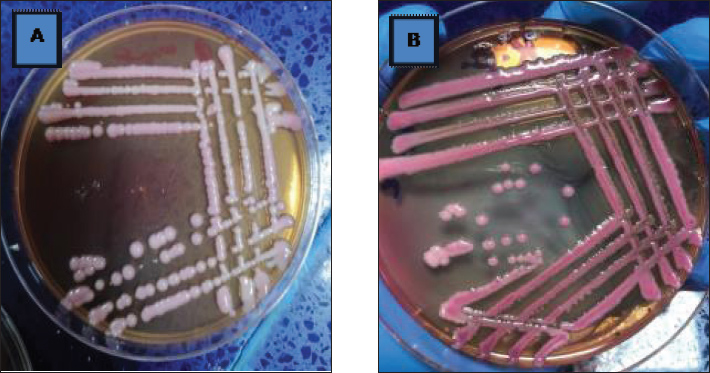

| Research Article | ||
Open Vet. J.. 2025; 15(12): 6842-6850 Open Veterinary Journal, (2025), Vol. 15(12): 6842-6850 Research Article Bacteriological and histopathological study of Raoultella planticola in local rabbits with respiratory distressKhudhair A. Hussein1, Asmaa H. Abdullah2, Alahmer M. A.3, Murtadha Abbas*41Department of Anatomy, Histology, University of Fallujah College of Medicine, Baghdad, Iraq 2Department of Microbiology, University of Baghdad College of Veterinary Medicine, Baghdad, Iraq 3Department of Anatomy, Histology, and Embryology, Faculty of Veterinary Medicine, University of Kufa, Najaf, Iraq 4Department of Public Health, Faculty of Veterinary Medicine, University of Kufa, Najaf, Iraq *Corresponding Author: Murtadha Abbas. Department of Public Health, Faculty of Veterinary Medicine, University of Kufa, Najaf, Iraq. Email: murtadhaa.alghazali [at] uokufa.edu.iq Submitted: 30/07/2025 Revised: 10/11/2025 Accepted: 20/11/2025 Published: 31/12/2025 © 2025 Open Veterinary Journal
AbstractBackground: The bacteriological and histopathological study of Raoultella planticola in local rabbits is not presented in previous research. There is no specific information about studying this bacterium in local rabbits. Hypothesis: The present study was based on bacteriological and histopathological changes in the trachea and lungs of local rabbits, as the samples were collected from 50 unhealthy local rabbits that appeared to be suffering from respiratory signs. Aims: To study the bacteria that were isolated for the first time from sheep suffering from respiratory infections, and diagnose them through VITEk2. Methods: We injected the isolated bacteria into (50) group of local rabbits (Oryctolagus cuniculus) and studied the histopathological changes in the trachea and lungs. Due to their similar morphological characteristics, our investigation reported this bacterium as Gram-negative rods. Then used the VITEK2 system to confirm the species of bacteria (93% Probability). Results: The animals clinically showed results (dullness with nasal and ocular discharge and cough). Then, euthanasia was performed to sacrifice animals seven days post-infection. The trachea and lungs were used in a histopathological study using routine Hematoxylin and Eosin stained. In this study, emphysema and bronchitis are often grouped under the heading of chronic obstructive pulmonary disease (COPD). Conclusion: Raoultella planticola infections are uncertain, and further studies are required. The previous difficulties in the identification of R. planticola may be explained by the introduction of more detailed identification techniques, which are explained in the present study. The conclusion of this study also provides that Raoultella planticola causes mild to moderate emphysema in local rabbits. Keywords: Respiratory system, Oryctolagus cuniculus, Raoultella planticola, Parenchyma, Alveoli. IntroductionRaoultella planticola is a Gram-negative, non-motile, aerobic, encapsulated bacterium belonging to the Enterobacteriaceae family (Chun et al., 2014). In Iraq, local rabbits have a second small pair of upper incisors (Harcourt-Brown, 2002). The rabbits among the laboratory animals have been used as an experimental model for research (Ghoshal and Bal, 1989). It belongs to the genus Raoultella under the Enterobacteriaceae family. Two species are clinically important (Sahu et al., 2020). The microbiological identification of R. planticola remains a challenge even after 30 years of its identification (Howell and Fakhoury, 2017). The gastrointestinal tract and the upper respiratory tract are the typical reservoirs of R. planticola (Sękowska, 2017). Infections related to rare pathogens are very challenging to treat due to a lack of enough data in the medical literature (Sahu et al., 2020). These strains can act as a reservoir for these resistance genes (Demiray, et al., 2017). The lung is a soft, compact, and spongy mass of tissues lying in the pleural cavity within the thorax. Each lung is covered by a fold of coelomic epithelium formed of two layers, a layer which in contact with the organ (visceral pleura) and that lines the chest wall (parietal pleura). Between these two layers of pleura, there is a pleural space, which is a potential space containing a small amount of fluid. Each lung is divided into lobes (Ramchandi et al., 2001). Klebsiella pneumoniae is a type of gram-negative bacteria that is normally found in the human intestines without causing any disease. However, if it enters other systems of the body, it can cause different types of healthcare-associated infections, including pneumonia, bloodstream infections, wound or surgical site infections, and meningitis (Centers for Disease Control and Prevention 2010). This research aims to study the Raoultella planticola that were isolated for the first time from respiratory infections, then confirmation by the VITEK2 system, and study the morphological characteristic. Materials and MethodsSamples were collected from 50 animals that appeared suffering from respiratory signs, and in the laboratory used routine steps to the identification of bacteria culturing, gram stain, and urease test. After that, the VITEK2 system was used to confirmed the species of Raoultella planticola, VITEK2 system has two test depending on the kit that we used. The first is a test of the biochemical reaction of bacteria with a chemical substance, and the second is a test of the resistance of bacteria to antibiotics. The antibiotics profile will be mentioned later. After that, the isolated bacteria were diluted and injected into 5 local rabbits regardless of sex in the Miles and Misra method to get the minimal dose that can cause infection (5 animals used for control) in the current study. The rabbits were scarified under good health conditions and followed the appropriate instructions of the animal ethics of the University of Baghdad College of Veterinary Medicine in Iraq. Finally collected specimens for the histology study of the respiratory system, the trachea, bronchus, and lungs. Histopathological aspect of the studyThe first step after samples collection is fixation by formaldehyde 10% then dyhydration via ethanol (70%, 80%, 90%, and 100%) for 2 hrs each of step. After that xylen was used as a clearing agent for 2 hrs. Then the samples were impregnated in melted paraffin wax (55°C–58°C) for 2hrs. Each piece of sample was embedded in paraffin wax and finally cut into sections (5–6 µm thickness) by using the rotary microtome (Microtome Bright 5030). The sections were stained with haematoxylin and eosin for routine histology (Suvarna et al., 2019). All stained slides were examined under the light microscope and photographed with a digital camera (USB) connected to the computer, camera should adjusted, and setliy should be fixed throughout all steps of capturing with different magnification powers. The slides were captured directly from computer at various adjustment powers (x10, x40, x100, and x400) to evaluate the histopathological features. The examination and photograph were conducted at histopathology and microbiological Lab. College of Medicine/University of Fallujah. The histopathological and staining techniques that used were as following, Harris Hematoxylin and Eosin stain (H&E): This stain was used to detect the general features of the tissue (Luna, 1968; Suvarna et al., 2013). Ethical approvalThis study was conducted in conformity with the rules of the Animal Ethics Committee of the Faculty of Veterinary Medicine at the University of Kufa (license number: 27735 in 13/12/2022). ResultsBacteriological studyTo study the pathogenesis of Raoultella planticola through its natural route of infection (nasal route), an experimental infection was conducted using a dose of 159,000 CFU/mL. Ten healthy rabbits were divided into two subgroups: a control group (5 healthy animals) and an infected group (5 healthy animals inoculated intranasally with Raoultella planticola at a dilution of 10−3. The infected animals exhibited clinical signs, including dullness, nasal discharge, and ocular discharge. After seven days post-infection, the rabbits were euthanized, and post-mortem examination revealed pulmonary emphysema at the mentioned dose. Bacteriological analysis confirmed Raoultella planticola as Gram-negative rods. The VITEK2 system identified the species with a 93% probability, and 23 samples were positive. The isolates Raoultella planticola were then injected into local rabbits (regardless of sex) after dilution using the Miles and Misra method to determine the minimal infective dose (intranasal 10−3, 2.5 ml instillations). Antimicrobial susceptibility testingDisk diffusion susceptibility testing was performed following Bernal and Guzmán (1984) and Clinical and Laboratory Standards Institute (CLSI, 2023) guidelines. Fourteen antimicrobial agents were tested against Raoultella planticola: • Amikacin • Amoxicillin/Clavulanic acid • Cefixime • Ceftriaxone • Chloramphenicol • Ciprofloxacin • Gentamicin • Imipenem • Meropenem • Nitrofurantoin • Piperacillin • Streptomycin • Tetracycline • Trimethoprim The average inhibition zone diameters were recorded, and results were interpreted according to CLSI standards (Table 2). Table 2. VITEK2 result show susceptibility of Raoultella planticola.
The current study demonstrated that Raoultella planticola exhibits mild pathogenicity when administered via the intranasal route in rabbits. The observed clinical signs (dullness, nasal and ocular discharge) and pathological findings (pulmonary emphysema) suggest that this bacterium can induce respiratory infection under experimental conditions. These et al findings align with Podschun (1998), who reported that Raoultella planticola is an environmental bacterium commonly found in water, soil, and plants, capable of colonizing humans and animals. The bacterium is a facultative anaerobic Gram-negative bacillus belonging to the Enterobacteriaceae family. It forms mucoid colonies on MacConkey agar due to polysaccharide capsule production (Figs. 1 and 2), making it morphologically and biochemically similar to Klebsiella spp. (Table 1).
Fig. 1. Urease test.
Fig. 2. A Comparison between Colonies of klebsiella pneumonia (A) culturing on MacConkey agar which appear as mucoid dark pink colony and Colonies of Raoultella planticola (B ) culturing on MacConkey agar appear as mucoid pink colonies Table 1. VITEK2 result show presence of Raoultella planticola.
The Vitek2 system provided reliable identification (93% probability), supporting the accuracy of the isolates used in this study. The antimicrobial susceptibility profile revealed varying resistance patterns, which may have clinical implications for treatment strategies. Further studies are needed to explore the virulence mechanisms and potential zoonotic risks associated with Raoultella planticola. Histopathological resultsHistological examination of lung tissue revealed emphysema and atelectasis (Fig. 6A and B). Emphysema was characterized by permanent enlargement of air spaces distal to the terminal bronchioles, accompanied by destruction of alveolar walls without significant fibrosis.
Fig. 3. Ventral view of lung for control group show (black arrow) trachea (green arrow) right lung.
Fig. 4. The trachea (control group ) show (black arrow tracheal cartilage) and (red arrow connective tissue).
Fig. 5. Control group (A) trachea (1)mucosal layer has ciliated pseudostratified epithelia (2)tracheal gland (3) Hyaline cartilage and (B) lung show (4)Alveolar sac (5) terminal bronchioles and had no pathological change of organ H&E stain 400X 200X respectively
Fig. 6. Group of infected rabbits lung (A) Bronchiols show emphysema aggregation of lymphocytic cell (black arrow)( B) show emphysema structure atelectasis (black arrow) H&E stain 400X and lung H&E stain 200X. Gross examination of sacrificed animals (group of infected rabbits) showed hemorrhage in the upper respiratory tract (Fig. 3). The trachea exhibited a semi-circular hyaline cartilage structure (Fig. 4), and the bronchi branched into left and right bronchioles, consistent with typical mammalian respiratory anatomy. Normal histological details of trachea of control group• Tunica mucosa • Tunica submucosa • Tunica adventitia • C-shaped hyaline cartilage (Fig. 5A) • score lesion of Pathological Changes • Emphysema was observed in 3 out of 5 cases (60%) (Fig. 4). • No pathological changes were seen in 2 cases (40%). • Vascular changes, including congestion, thrombosis, and alveolar hemorrhage, were noted in 10% of affected cases. Comparative morphologyLight microscopy analysis confirmed Gram-negative rods for Raoultella planticola. However, differentiation from Klebsiella spp. was challenging due to morphological similarities (Fig. 2A and B). The histological findings of emphysema and atelectasis align with Blagojević et al. (2018), who described similar structural changes in respiratory infections. The observed hemorrhage and vascular congestion support Castro et al. (2001), who linked these changes to bacterial-induced trauma. The 60% incidence of emphysema suggests that Raoultella planticola primarily induces chronic obstructive pulmonary disease (COPD)-like lesions, differing from Sarhad (2011), who reported fibrinous pleuropneumonia as the dominant pathology. This discrepancy may stem from differences in infection routes or host susceptibility. The short respiratory passage and direct bronchial branching in rabbits (Abdelsalam and Al Sadrani, 2015) likely contribute to higher lung infection rates. Additionally, the similarity between Raoultella and Klebsiella (Alampoondi Venkataramanan et al., 2021) complicates microscopic differentiation, necessitating advanced diagnostic methods like Vitek2.Contrary to Vinshia, J. J., (2024), this study found no fibrinous bronchopneumonia, instead emphasizing edema and congestion (Das and Bhagman, 1997). The reclassification of Raoultella from Klebsiella prior to 2001 further underscores the need for precise microbiological identification (Fig. 8). This study highlights Raoultella planticola's potential to cause respiratory pathology, warranting further investigation into its zoonotic risks.
Fig. 7. The lung is show emphysema group of infected rabbits show moderate fibroplasia of arterioles. (black arrow) and tertiary bronchioles (blue arrow). H&E stain 400X (Castro et al., 2001).
Fig. 8. Group of infected rabbits show(A) arterioles moerate perivascular mononuclear cells infiltration with evidence of vasculitis (black arrow) H&E stain 400X. and B show tertiary bronchioles (blue arrow)with dilated pulmonary arterioles(red arrow) and the lung is show emphysema. H&E stain 100X. DiscussionThis comprehensive examination reveals that when rabbits were given intranasal doses of Raoultella planticola, it led to a mild yet noticeable respiratory infection. The evidence is clear—clinical signs such as dullness, nasal discharge, and watery eyes were apparent. What's more, significant pathological changes were observed, particularly in the lungs, with pulmonary emphysema and atelectasis appearing in 60% of the cases examined. Add to that the striking visible signs of hemorrhage, and it paints quite a concerning picture of the infection's impact. The bacterium's ability to cause disease, boosted by its protective polysaccharide capsule and its close resemblance to Klebsiella species, was convincingly verified using the VITEK2 system. However, when we dive into the histopathological findings, we see hints of emphysema and some intriguing vascular changes that resonate with certain literature; yet, there’s a twist—this evidence points more toward a COPD-like condition rather than the fibrinous pneumonia that's been noted in other studies. Moreover, the antimicrobial susceptibility profile painted a complex picture, revealing varying degrees of resistance that certainly pose difficulties for treatment. All in all, these findings affirm that R. planticola can trigger respiratory issues through the nasal route, shedding light on the pressing need for accurate diagnostics and further exploration into its virulence and potential to jump from animals to humans. ConclusionRaoultella planticola are very similar in phenotype to Klebsiella spp. in epidemiology and the clinical signs in respiratory infection of rabbit. The R. planticola causes mild to moderate emphysema in local rabbit. The previous difficulties in the identification of R.planticola and known of more detailed may needed PCR technique to confirm diagnosis. Intranasal infection was the effective route and the main pathological changes observed in the respiratory system characterized by presence of atelectasis indicated of emphysema. Further studies of molecular sequences are required. AcknowledgmentsThe authors extend their sincere thanks to the Faculty of Veterinary Medicine/the University of Kufa for their unwavering support. The authors also intensely appreciate the contributions of the veterinarians and staff at the Veterinary Hospital Laboratory and Wasit Abattoir for their technical support and collaboration in sample collection and analysis. Authors' ContributionAll listed authors have made significant intellectual and academic contributions to this study. Each author has reviewed and approved the final manuscript for publication. Competing interestsThere are no conflicts of interest numerous of the authors concerning the publishing this manuscript. FundingNone. Data availabilityAll the datasets formed or examined during this work are included in the publication. ReferenceAbdelsalam, E.B. and Al Sadrani, A.A. 2015. Incidental findings of pathological significance in pneumonic lungs of sheep in Al Qassim Area, Kingdom of Saudi Arabia: an abattoir survey. Comparative. Clin. Pathol. 24, 951–955. Alampoondi Venkataramanan, S.V., George, L., Sahu, K.K. and Abraham, G.M. 2021. A 5-Year Retrospective analysis of Raoultella planticola bacteriuria. InfectDrug. Resist. 1989, 1989–2001. Bagley, S.T., Seidler, R.J. and Brenner, D.J. 1981. Klebsiella planticola sp. nov.: a new species of Enterobacteriaceae found primarily in nonclinical environments. Curr. Microbiol. 6(6), 105–109. Bancroft, J.D., Layton, C. and Suvarna, S.K. 2013. Bancroft's theory and practice of histological techniques. Churchill Livingstone Elsevier. Nottingham, UK: Elsevier. Blagojević, M., Božičković, I., Ušćebrka, G., Lozanče, O., Đorđević, M., Zorić, Z. and Nešić, I. 2018. Anatomical and histological characteristics of the lungs in the ground squirrel (Spermophilus citellus). Acta Veterinaria Hungarica 66(2), 165–176. Castro, P., Chiu, P., Kremenek, T. and Muntz, R. A probabilistic room location service for wireless networked environments. In Ubicomp 2001: Ubiquitous Computing: International Conference Atlanta Georgia, USA, September 30–October 2, 2001 Proceedings 3,2001 Springer Berlin Heidelberg, Atlanta, Georgia, 3, pp 18–34. Chun, S., Yun, J.W., Huh, H.J. and Lee, N.Y. 2014. Low virulence? Clinical characteristics of Raoultella planticola bacteremia. Infection 42, 899–904. Das, B., Rao, A.R. and Madhubala, R. 1997. Difluoromethylornithine antagonizes taxol cytotoxicity in MCF-7 human breast cancer cells. Oncol. Res. Featuring. PreClin. Clin. Cancer. Therapeutics. 9(11-12), 565–572. Demiray, T., Koroglu, M., Ozbek, A. and Altindis, M. 2017. A rare cause of infection, Raoultella planticola: emerging threat and new reservoir for carbapenem resistance. Infection 44, 713–717. enters for Disease Control and Prevention. (2010). Klebsiella pneumoniae in healthcare settings. Available via https://www. cdc. gov/hai/organisms/klebsiella/klebsiella. html (accessed: 2019, May 20). Eroschenko, V.P. and Di Fiore, M.S. 2013. DiFiore's atlas of histology with functional correlations. Philadelphia, PA: Lippincott Williams & Wilkins, pp: 263–6. Freney, J., Fleurette, J., Gruer, L. D., Desmonceaux, M., Gavini, F., and Leclerc, H. 1984. Klebsiella trevisanii colonisation and septicaemia. Georgi. and Anderson. 1975. The Cornell Veterinarian. Cornell Vet. 66, 309–323. Ghoshal, N.G. and Bal, H.S. 1989. Comparative morphology of the stomach of some laboratory mammals. Lab. Animals 23(1), 21–29. Harcourt-Brown, F. 2002. Textbook of rabbit medicine. Elsevier Health Sciences.. Howell, C. and Fakhoury, J. 2017. A case of Raoultella planticola causing a urinary tract infection in a pediatric patient. Translational Pediatrics 6(2), 102. Jiménez Castro, D., Pérez-Rodríguez, E., Montaner, L., Flores, J. and Díaz Nuevo, G. 2001. Diagnostic value of D dimer in pulmonary embolism and pneumonia. Respiration 68(4), 371–375. Luna, L.G. 1968. Manual of histologic staining methods of the Armed Forces Institute of Pathology. In Manual of histologic staining methods of the Armed Forces Institute of Pathology. McGraw-Hill, New York: NY, pp: xii–258. Podschun, R., Acktun, H., Okpara, J., Linderkamp, O., Ullmann, U. and Borneff-Lipp, M. 1998. Isolation of Klebsiella planticola from newborns in a neonatal ward. J. Clin. Microbiol. 36(8), 2331–2332. Ramchandani, V.A., Bosron, W.F. and Li, T.K. 2001. Research advances in ethanol metabolism. Pathologie. Biologie. 49(9), 676–682. Sahu, K., Sherif, A. and Davaro, R. 2020. A rare cause of cellulitis: photobacterium damselae. J. Microsc. Ultrastructure 8(1), 25–26. Sarhad, A.N.S. 2011. Pathogenesis of Pasteurella multocida in Rabbits by Intra-nasal and Intra-ocular infection. Iraqi. J. Vet. Med. 35(1), 42–53. Sękowska, A. 2017. Raoultella spp.—clinical significance, infections and susceptibility to antibiotics. Folia. Microbiologica. 62(3), 221–227. Suvarna, S.K., Layton, C. and Bancroft, J.D. 2019. Theory and practice of histological techniqueseighth. Oxford, UK: Elsevier Health Sci. Vinshia, J.J., Padmavathy, K. and Sathyapriya, B. 2024. Comparison of the VITEK® 2 system with conventional methods for species identification and antimicrobial susceptibility pattern of staphylococcal carrier isolates. Int. Res. J. Multidisciplinary. Scope. (IRJMS). 5(2), 940–948. Woodman, C.B., Collins, S., Winter, H., Bailey, A., Ellis, J., Prior, P., Yates, M., Rollason, T.P. and Young, L.S. 2001. Natural history of cervical human papillomavirus infection in young women: a longitudinal cohort study. Lancet 357(9271), 1831–1836. | ||
| How to Cite this Article |
| Pubmed Style Hussein KA, Abdullah AH, Alahmer MA, Abbas M. Bacteriological and histopathological study of Raoultella planticola in local rabbits with respiratory distress. Open Vet. J.. 2025; 15(12): 6842-6850. doi:10.5455/OVJ.2025.v15.i12.64 Web Style Hussein KA, Abdullah AH, Alahmer MA, Abbas M. Bacteriological and histopathological study of Raoultella planticola in local rabbits with respiratory distress. https://www.openveterinaryjournal.com/?mno=274229 [Access: January 25, 2026]. doi:10.5455/OVJ.2025.v15.i12.64 AMA (American Medical Association) Style Hussein KA, Abdullah AH, Alahmer MA, Abbas M. Bacteriological and histopathological study of Raoultella planticola in local rabbits with respiratory distress. Open Vet. J.. 2025; 15(12): 6842-6850. doi:10.5455/OVJ.2025.v15.i12.64 Vancouver/ICMJE Style Hussein KA, Abdullah AH, Alahmer MA, Abbas M. Bacteriological and histopathological study of Raoultella planticola in local rabbits with respiratory distress. Open Vet. J.. (2025), [cited January 25, 2026]; 15(12): 6842-6850. doi:10.5455/OVJ.2025.v15.i12.64 Harvard Style Hussein, K. A., Abdullah, . A. H., Alahmer, . M. A. & Abbas, . M. (2025) Bacteriological and histopathological study of Raoultella planticola in local rabbits with respiratory distress. Open Vet. J., 15 (12), 6842-6850. doi:10.5455/OVJ.2025.v15.i12.64 Turabian Style Hussein, Khudhair A., Asmaa H. Abdullah, M. A. Alahmer, and Murtadha Abbas. 2025. Bacteriological and histopathological study of Raoultella planticola in local rabbits with respiratory distress. Open Veterinary Journal, 15 (12), 6842-6850. doi:10.5455/OVJ.2025.v15.i12.64 Chicago Style Hussein, Khudhair A., Asmaa H. Abdullah, M. A. Alahmer, and Murtadha Abbas. "Bacteriological and histopathological study of Raoultella planticola in local rabbits with respiratory distress." Open Veterinary Journal 15 (2025), 6842-6850. doi:10.5455/OVJ.2025.v15.i12.64 MLA (The Modern Language Association) Style Hussein, Khudhair A., Asmaa H. Abdullah, M. A. Alahmer, and Murtadha Abbas. "Bacteriological and histopathological study of Raoultella planticola in local rabbits with respiratory distress." Open Veterinary Journal 15.12 (2025), 6842-6850. Print. doi:10.5455/OVJ.2025.v15.i12.64 APA (American Psychological Association) Style Hussein, K. A., Abdullah, . A. H., Alahmer, . M. A. & Abbas, . M. (2025) Bacteriological and histopathological study of Raoultella planticola in local rabbits with respiratory distress. Open Veterinary Journal, 15 (12), 6842-6850. doi:10.5455/OVJ.2025.v15.i12.64 |